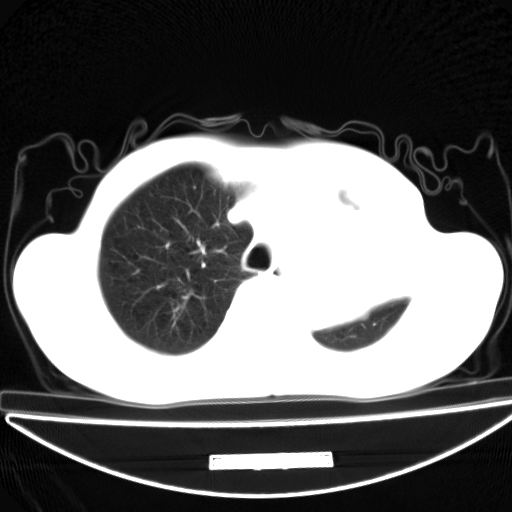
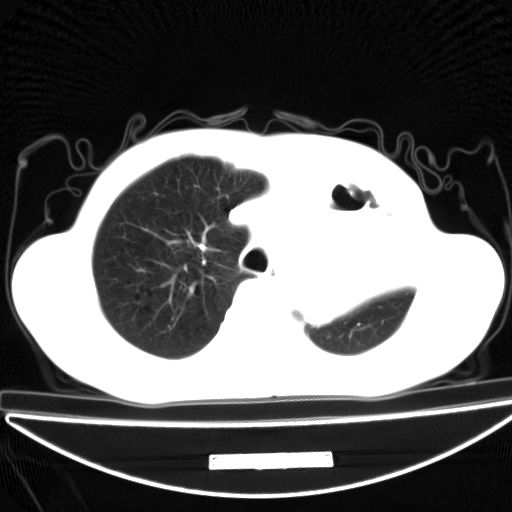
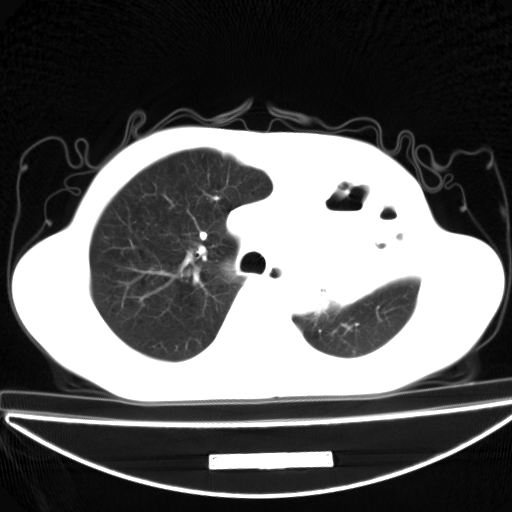
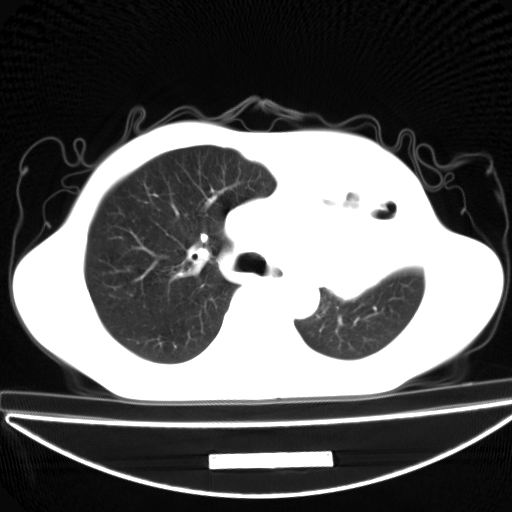
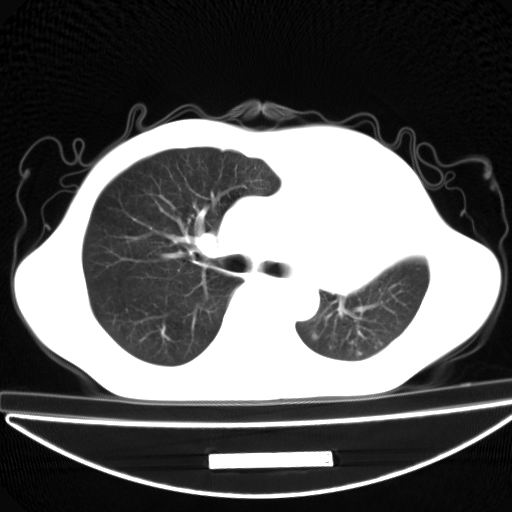
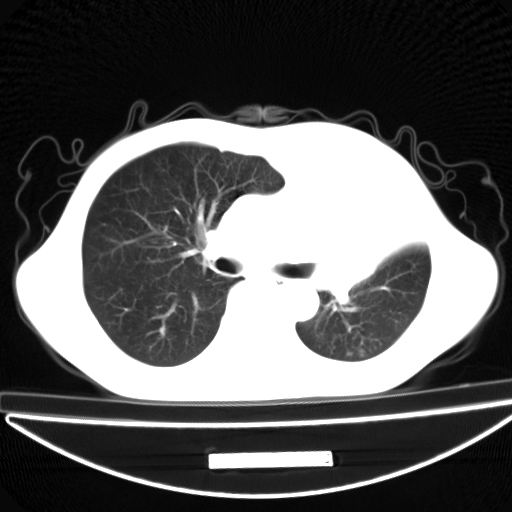
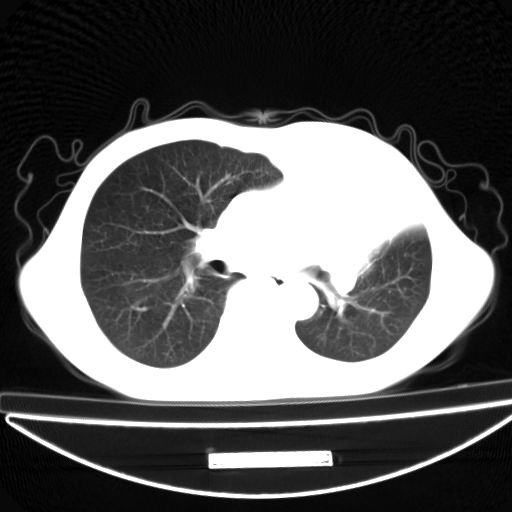
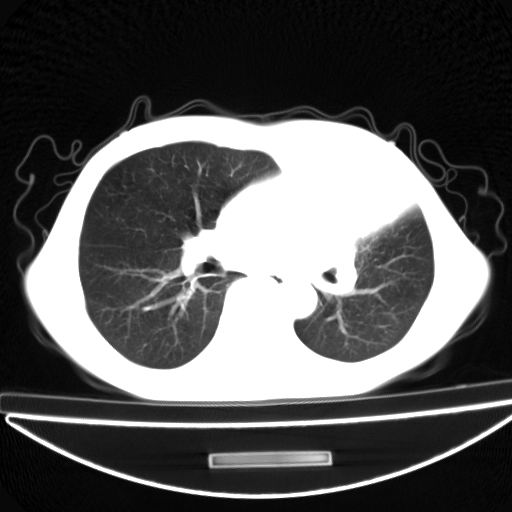
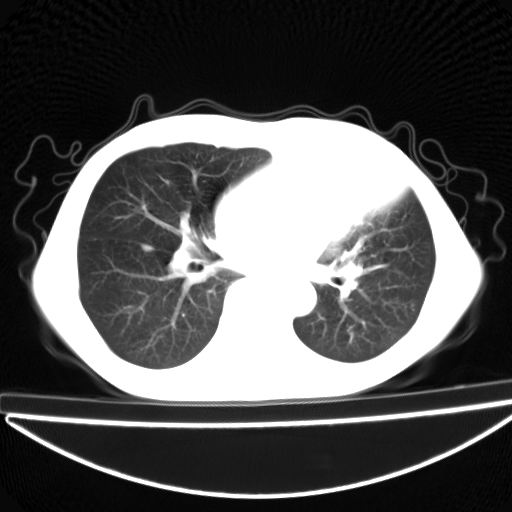
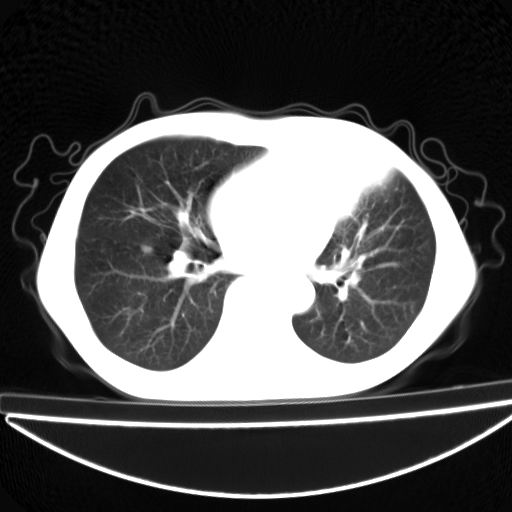
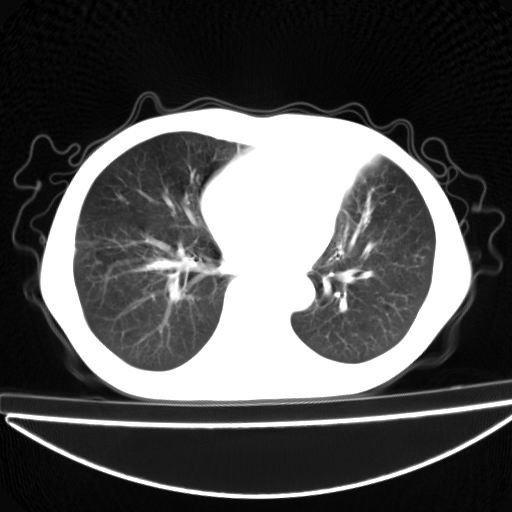
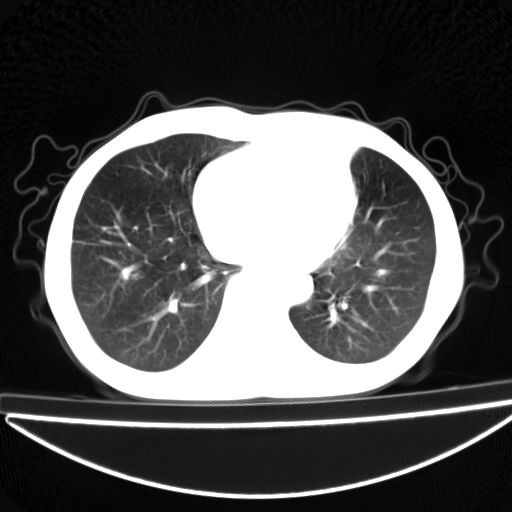
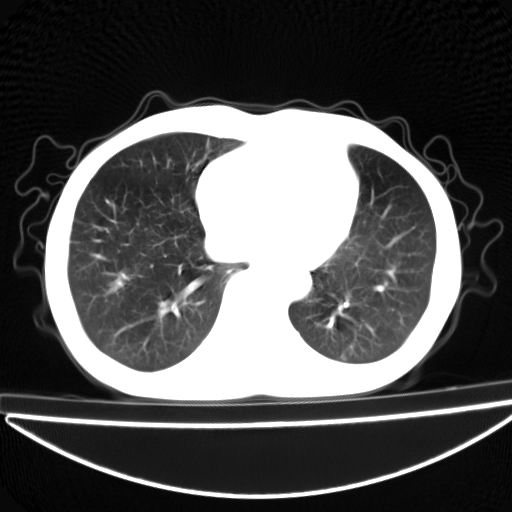
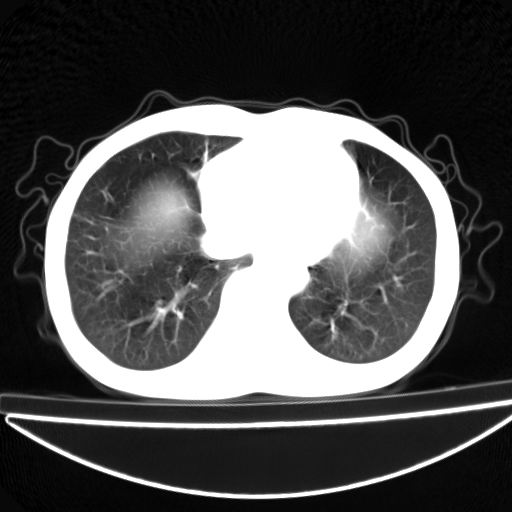
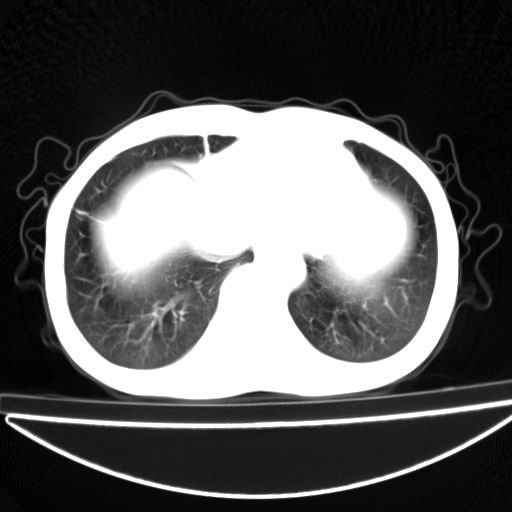

以下是引用杀毒软件在2009-4-28 17:58:00的发言:[br]考虑----左肺慢性肺脓肿形成继发上叶含气不良---抗炎后复查---待排肿瘤所致[br][br][本贴已被 杀毒软件 于 2009-4-28 18:01:26 修改过]
以下是引用杀毒软件在2009-4-28 17:58:00的发言:[br]考虑----左肺慢性肺脓肿形成继发上叶含气不良---抗炎后复查---待排肿瘤所致[br][br][本贴已被 杀毒软件 于 2009-4-28 18:01:26 修改过]
| 欢迎光临 医影在线 (http://bbs.radida.com/bbs/) | Powered by Discuz! X3.2 |